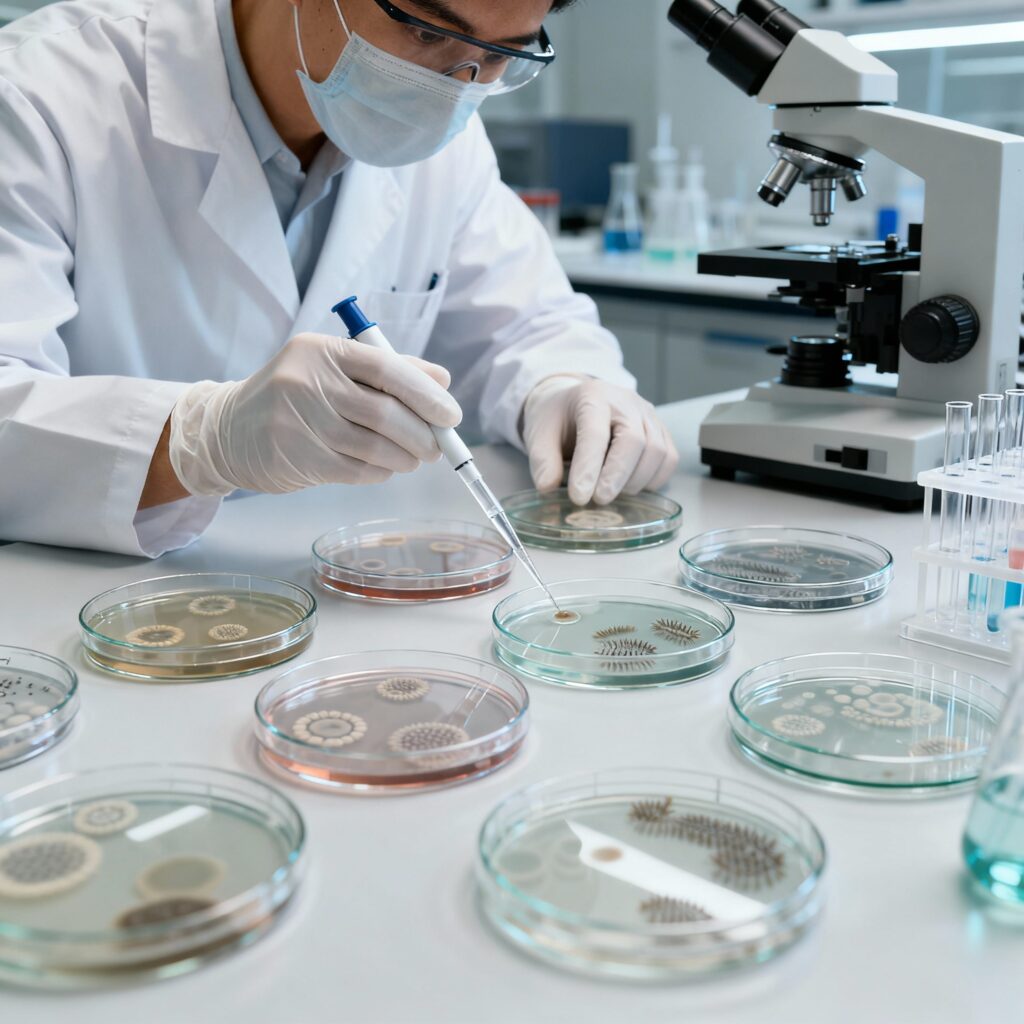

Bioburden Testing and Microbial Quality Assessment of Herbal and AYUSH Products
Expert Research Consulting at My Career Ladder
At My Career Ladder, we understand the critical importance of microbial safety in herbal and AYUSH medicinal products. Our dedicated Pharmaceutical Microbiology Laboratory offers comprehensive bioburden testing and microbial quality assessments to ensure that your herbal formulations meet the highest standards of safety and regulatory compliance.
Our state-of-the-art laboratory facilities include:
- Bioburden Testing Lab equipped for total viable count (TVC) determination
- Specialized Microbiology Culture Media for selective growth
- Autoclave and Laminar Flow Cabinet for sterile processing
Detailed Methodology:
- Sample Collection: We carefully source marketed AYUSH product samples, handling them with stringent aseptic techniques to preserve integrity.
- Total Viable Count (TVC) Determination: Using standard plate count methods, we quantify the microbial load to ascertain product cleanliness.
- Pathogen Detection: Targeted screening for harmful microbes including Escherichia coli, Salmonella species, and Staphylococcus aureus to protect end-users.
- PCR-Based Microbial Identification: Advanced molecular techniques ensure rapid and precise confirmation of microbial species present.
- Compliance Testing: Rigorous evaluation against WHO guidelines and Ministry of AYUSH standards guarantees your products adhere to national and international quality expectations.
- Risk Assessment & Recommendations: Our experts provide detailed reports highlighting microbial risks and offer insightful quality control measures to safeguard your products and reputation.
Ensuring the microbial safety of herbal and AYUSH products is a non-negotiable requirement in today’s health-conscious market. With My Career Ladder’s expert bioburden testing and microbial assessment services, you demonstrate commitment to consumer health and regulatory excellence.
Partner with My Career Ladder to elevate your research quality and product safety. Visit www.MyCareerLadder.in to learn more about our advanced research support and consulting services tailored for pharmaceutical and life science innovators.
